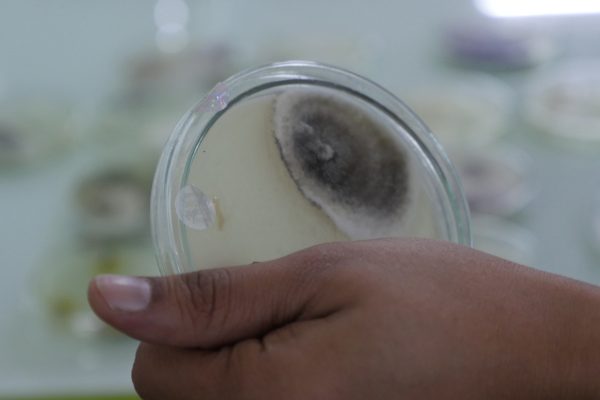
Adaptive-Symbiotic-Technologies-Photos_028

Bioensure fungal seed and plant treatment for water-stress resilience
Innovation Type:
Water-Food
Product Segment:
Water – Salinity
Country of Incorporation:
United States
Country of Implementation:
Argentina
Australia
India
United States
Challenges
Current changes in climate conditions are causing agricultural crops to face increased environmental stresses. Warmer temperatures, drought and poor water quality are causing decreased crop yields and crop values. This can be disastrous for farming communities whose subsistence depends on healthy crop income to support their families. With global crop yields decreasing due to climate change, a workable solution is imperative to support an increasing world population.
Solutions
Through years of plant research in harsh growing environments (deserts, geothermal pools, salty shorelines) Adaptive Symbiotic Technologies has discovered symbiotic fungi that live naturally inside plants that thrive in these severe conditions. The fungi increase the plants stress tolerance to some very difficult growing conditions. Based on this symbiotic relationship we started producing a natural fungal seed and plant treatment called BioEnsure to help growers’ combat abiotic stress in their crops. When sprayed onto seeds or leaves it can help crops adapt to water-related stress, and crops require up to 50% less water.
Our model is to distribute BioEnsure to rural farming villages through women-lead distribution systems. We would like to develop small-scale seed treating franchises that are operated by local women, allowing them to earn independent incomes.
Milestones and Achievements
In the first year of its participation in the Securing Water for Food program, BioEnsure® users in India saw a 29% increase in crop yields. Even those farming in difficult growing conditions are seeing an increase in plant resiliency. Currently, BioEnsure® is being applied to 4 food crops—okra, maize, wheat, and millet. Securing Water for Food isn’t the only program that believes in Adaptive Symbiotic Technologies’ innovation. The innovator has leveraged more than $2 million in outside funding in the first year.